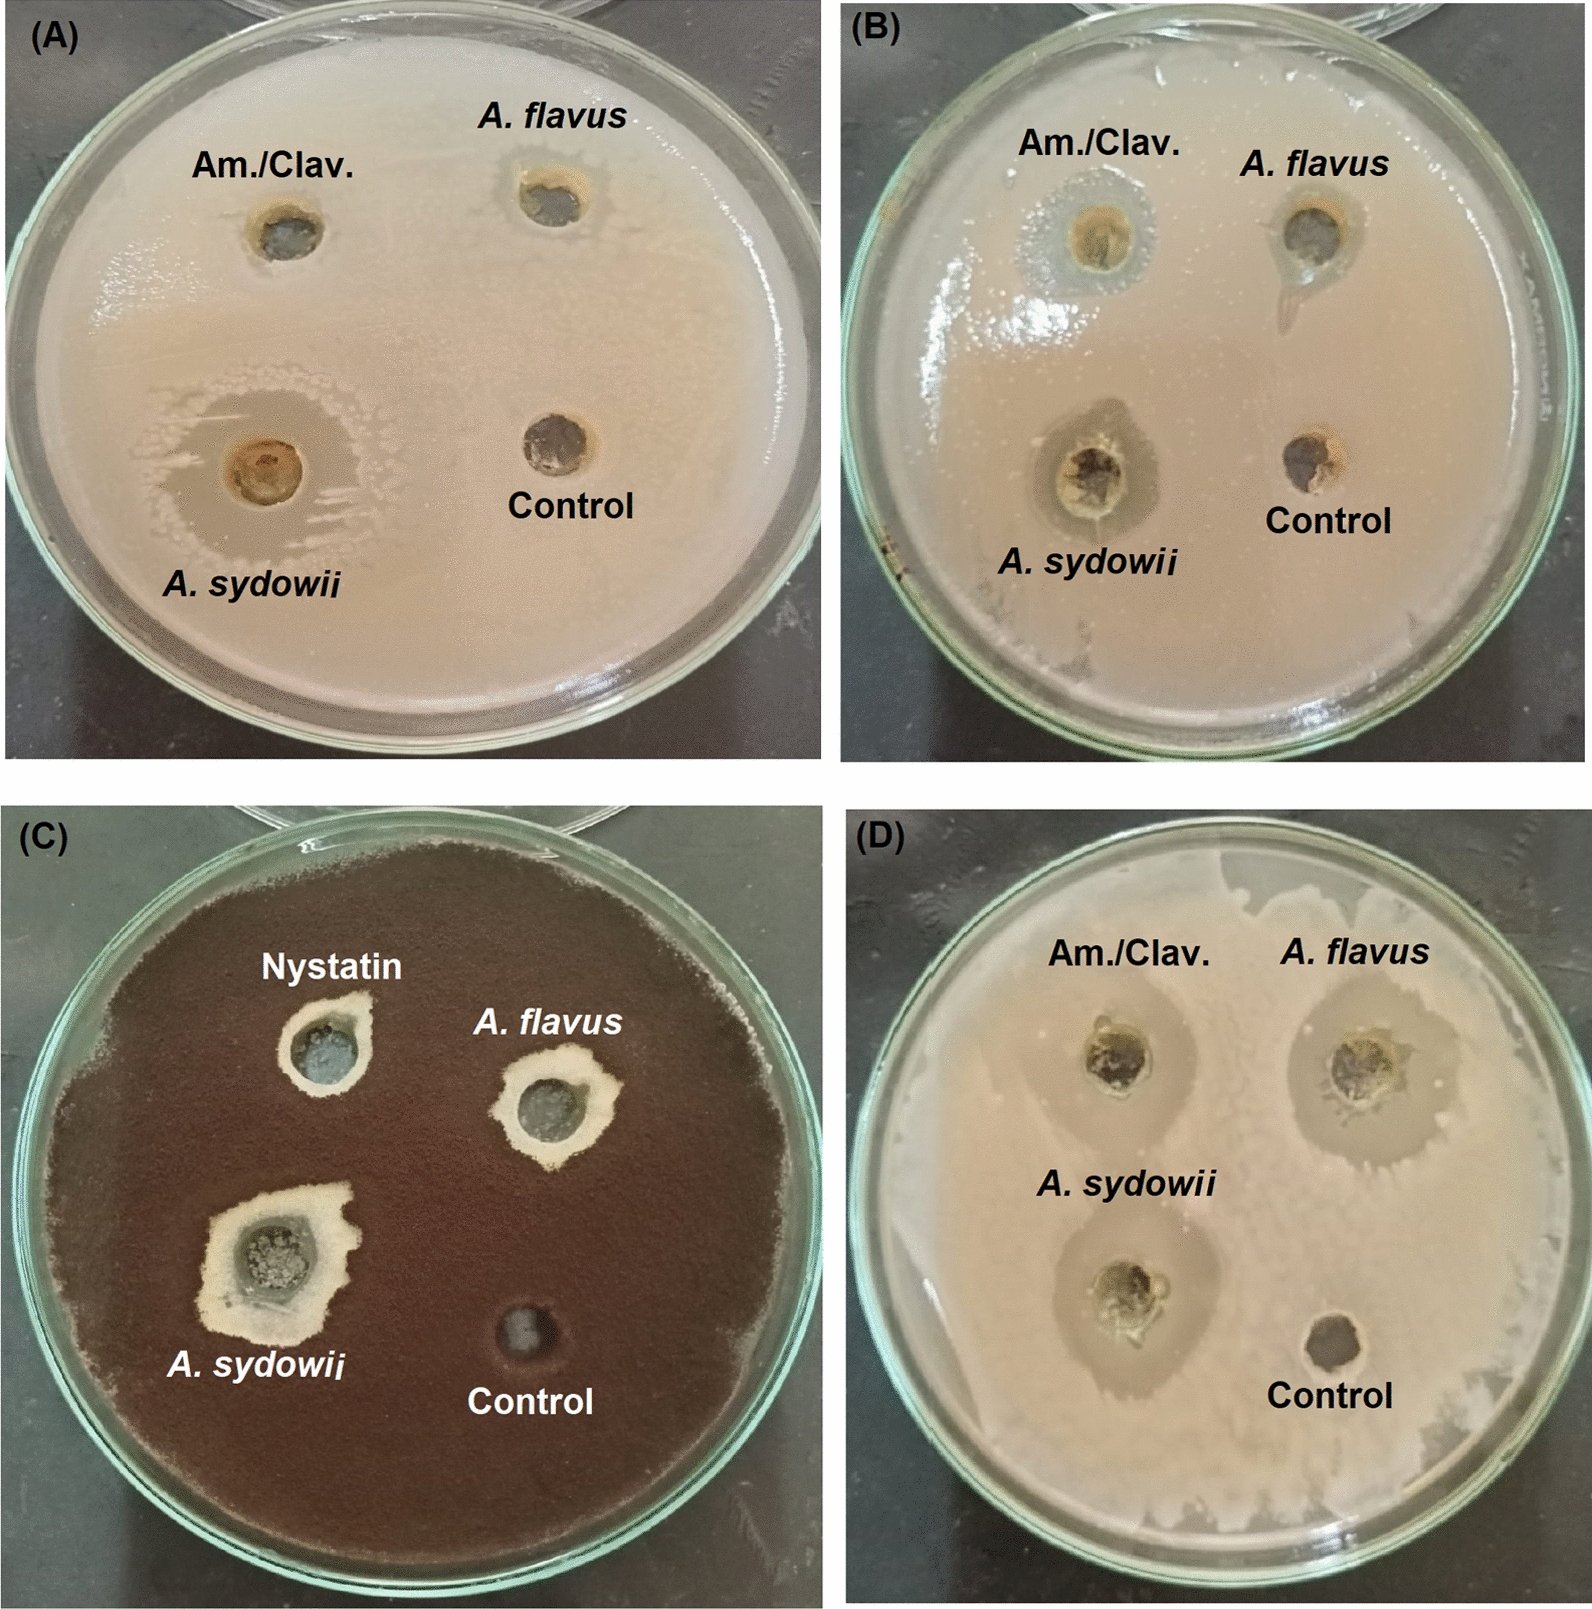
Fig. 1

Abstract
The search for new bioactive compounds with innovative modes of action and chemistry are desperately needed to tackle the increased emergence of drug-resistant microbes. With this view, this paper was conducted for the isolation, identification, and biological evaluation of fungal endophytes of eleven different plant species. A total of 69 endophytic strains were isolated and tested for the presence of bioactive metabolites with antifungal, antibacterial, anticancer, and antioxidant properties in their extracts. Upon screening, two promising strains were found to have all the before-mentioned activities. These strains were Aspergillus sydowii isolated from the bark of Ricinus communis and Aspergillus flavus isolated from the twigs of Psidium guajava. Major compounds present in extracts of the two strains were identified by GC-Mass analyses. Several well-known bioactive compounds as well as unreported ones were identified in the fungal extracts of the two strains. Furthermore, gamma irradiation (at 1000 Gy) of the fungal cultures resulted in improved bioactivities of extracts from the two strains. These findings recommend the two fungal strains as sources of antimicrobial, anticancer, and antioxidant compounds which may aid in the development of novel drugs. The presented research also explains the high-value of fungal endophytes as untapped sources of bioactive metabolites.
Keywords: Bioactives, Antioxidant, Antifungal, Antibacterial, Endophytes, Anticancer
Keypoints
Discovery of two promising fungal endophytes with divers’ range of bioactivities
Extracts of the two strains showed antimicrobial, anticancer, and antioxidant activities
Exposure to gamma rays at 1000 Gy significantly enhanced all the bioactivities.
Introduction
Natural bioactive compounds are considered the cornerstone in the development of high-value products. Their bioactivity has supported their applications in medicine, agriculture, and the food industry (Atanasov et al. 2021). The search for new bioactive compounds and the study of their potential biological activities has emerged as one of the most promising and ambitious developments in science (Karthikeyan et al. 2022). For example, there is a continuous need for new antibiotics due to the emergence of resistant microbes, and a global need for other drugs to target unmet clinical needs for a range of diseases (Miethke et al. 2021). The resistant microbes are potential threats to human and animal health with serious consequences. Hence, new natural compounds must be identified and developed now, more than ever, to meet this urgent and growing demand for novel drugs.
In natural products discovery programs, bioprospecting plants for novel bioactive compounds is ongoing, and such sources of bio-based products, represented a market share of 47% (Newman and Cragg 2016). However, using plants as a source of complex therapeutics brings with its drawbacks including low yields and sustainable supply, frequently leading to over-harvesting. The use of microorganisms instead of the plants themselves has emerged as a promising strategy for offering compounds with high therapeutic potential (Alvin et al. 2009). The utilisation of microbial communities, especially fungi, has several advantages which rendered it more robust than other strategies. For instance, the culture medium for fungal growth and metabolism is relatively cheap and simple, so, cells have gained remarkable attention because of their promising biotechnological potential and diversity (Janso and Carter 2010). Recent scientific efforts have been aimed at the bioprospection of the endophytic fungi (fungal community inside plant tissues) for the isolation of new antimicrobials and anticancer drugs (Kumar and Mongolla 2018; Saha et al. 2019). Endophytic fungi have been studied mainly as sources of new bioactive compounds and secondary metabolites of their host plants with several applications in medicine, agriculture, and food industry (dos Santos et al. 2021; Mousa et al. 2021), as they proved to be untapped pools of novel bioactive molecules (Venugopalan and Srivastava 2015).
It is now known that most plants contain endophytic fungi that grow in plant tissues and aid nutrient assimilation, produce growth promoting metabolites, insect and pest repellents, but also antimicrobials which are indispensable for plant survival (Baron and Rigobelo 2022). As a consequence of co-evolutionary processes, these endophytes harbor an enormous metabolic potential to synthesize compounds with high bioactivity that can be exploited commercially (Nisa et al. 2015; and references therein). Moreover, they showed higher metabolic activity than their free counterparts (El-Sayed 2021). It is worthy here to mention that the possibility to find novel biologically active secondary metabolites from endophytic fungi is tremendous. For all of these reasons, we aim in this paper to unfold the untapped potential of endophytic fungi of some plant species as sources for bioactive compounds. Today, the bioprospecting research still needs much attention because few products from it are available in the pharmaceutical market (dos Santos et al. 2021). Moreover, several reports recommended the use of gamma rays as a physical mutagen to improve microbial cultures thereby developing hyper-producers of the bioactive metabolites of industrial significances (Parekh et al. 2000; El-Sayed 2021; Zaki and El-Sayed 2021). In this context, 69 fungal strains were isolated from different plant tissues and screened for the presence of bioactive metabolites with antifungal, antibacterial, anticancer, and antioxidant properties. GC–MS analysis of the fungal extracts was accomplished to identify the chemical constituents. Furthermore, the effect of gamma irradiation on bioactivities of extracts from the two strains was also adopted.
Materials and methods
Plant materials and isolation of fungal endophytes
Samples were removed by a sterile sharp blade from healthy plant parts. Table 1 presents the used plant species. Plant species were identified from different cultivated locations in Egypt. The collected plant samples were transported to the laboratory and used for isolation of fungal endophytes according to El-Sayed et al. (2020a). Samples were fragmented to small parts, successfully dipped in 70% ethanol (for 1 min) then 0.1% HgCl2 (for 1 min) to sterilize their surfaces, washed in sterile dist. water, and let to dry on a sterile filter paper. All parts were transferred aseptically to on the surface potato-dextrose (amended with streptomycin and tetracycline) agar plates and were incubated at 25 °C, then checked daily. The isolated cultures were checked for purity and stored in glycerol (15%) as a suspension of spores and mycelia at – 4 °C.
Table 1.
Host plants, isolated endophytic fungal genera, and antifungal, antibacterial, anticancer, and antioxidant activities of their crude extract
| Host plant | Endophytic fungal genera | ||||||||
|---|---|---|---|---|---|---|---|---|---|
| Aspergillus | Alternaria | Fusarium | Trichoderma | Lasiodiplodia | Acremonium | Cladosporium | Chaetomium | ||
| Azadirachta indica | L | – | 1 | – | – | – | 1O | – | – |
| T | – | – | – | – | – | – | 1 | – | |
| B | – | – | 1 | 1 | – | – | – | – | |
| Ricinus communis | L | – | – | – | – | – | – | – | – |
| T | – | 1 | – | 1 | – | – | – | – | |
| B | 1F,B,C,O | – | 1 | 1 | – | – | – | – | |
| Hibiscus rose-sinensis | L | – | – | 1 | – | – | – | – | 1 |
| T | 1 | 1 | – | 1 | – | – | – | – | |
| Psidium guajava | L | – | 1 | – | – | – | – | – | – |
| T | 1F,B,C,O | – | 1 | – | – | 1 | 1C,O | – | |
| B | 1 | 1 | – | 1 | – | – | 1 | – | |
| Malus domestica | L | 1 | 1 | – | – | – | – | – | 1 |
| T | – | – | – | 1O | – | – | 1 | ||
| B | – | 1 | – | – | – | – | – | – | |
| Citrus medica | L | 1 | 1B | – | – | – | 1 | 1 | – |
| T | – | – | – | – | – | – | – | – | |
| B | 1 | 1 | 1 | – | – | – | – | 1F,B | |
| Olea europaea | L | – | 1 | – | – | – | – | – | – |
| T | – | 1 | 1 | – | – | 1 | – | – | |
| B | – | – | 1 | 1 | – | – | 1O | – | |
| Cupressus sempervirens | L | – | 1 | 1 | 1 | – | – | – | – |
| T | – | 1 | – | – | – | 1 | – | 1 | |
| B | – | 1 | 1 | 1 | – | – | – | – | |
| Pinus sylvestris | L | 1F,B | 1 | – | 1 | – | – | – | – |
| T | – | – | – | – | – | 1 | – | – | |
| B | – | 1 | – | 1 | – | 1B | – | ||
| Mangi feraindicia | L | – | 1F,B | – | – | – | – | 1 | – |
| T | – | 1 | – | – | – | – | – | – | |
| B | – | – | – | 1 | – | – | – | – | |
| Terminalia arjuna | L | – | 1 | – | 1F,B | – | – | – | – |
| T | – | 1 | – | – | – | – | – | – | |
| B | – | – | – | – | 1 | – | – | – | |
| Total | 8 | 20 | 9 | 13 | 1 | 7 | 7 | 4 | |
PDA was used for endophytic fungi isolation
T Twig, L Leaf and B Bark
Fungal cultures were incubated for 7 days at 30 ℃
FIndicates antifungal activity, BIndicates antibacterial activity, CIndicates anticancer activity, and OIndicates antioxidant activity. Nystatin and Amoxicillin/Clavulanic acid were used as standard antifungal and antibacterial at a concentration of 100 µg mL−1
Cultivation conditions and preparation of fungal culture extracts
Spore suspension for each fungal isolate was harvested from 7-days old culture and the final spore concentration was counted and adjusted to 106 mL−1 using a hemocytometer. 1 mL of this suspension was inoculated under aseptic conditions to 250 Erlenmeyer flasks containing 50 mL PD broth and incubated at 30 ℃ for 7 days.
After incubation, culture filtrate of each fungal isolate was extracted thrice with an equal amount of methylene chloride. The methylene chloride layers were separated by a separating funnel, pooled, passed over anhydrous sodium sulphate to remove any water. The methylene chloride layers were concentrated by evaporation using an IKA, RV10, Germany rotary evaporator under reduced pressure. The resultant dry film was carefully dissolved in HPLC-grade methanol and used for testing the antibacterial, antifungal, anticancer, and antioxidant activities.
Screening bioactivities of the isolated endophytes
The prepared crude extracts of the isolated endophytic fungi were used to evaluate their antibacterial, antifungal, anticancer, and antioxidant activities, as follows:
Antifungal and antibacterial sensitivity tests Antifungal and antibacterial potentials of the extracts were investigated according to Pongtharangkul and Demirci (2004) using the agar-well diffusion assay. The antifungal assay was against two human pathogens Aspergillus brasiliensis ATCC16404 and Candida albicans ATCC10231. Under the same conditions, a positive control of Nystatin (standard antifungal) and methanol only were also applied. Meanwhile, the antibacterial was evaluated against different human pathogenic bacteria Escherichia coli ATCC11229 and Staphylococcus aureus ATCC6538. Under the same conditions a positive control of Amoxicillin/Clavulanic acid (standard antibiotic) was applied. After incubation, zones of inhibition were measured carefully.
Antioxidant activity Crude extracts of the all the fungal isolates were tested for their antioxidant activities by the free radical scavenging assay according to the method described by Thaipong et al. (2006) performed using 2,2\-diphenyl picrylhydrazyl (DPPH, Sigma-Aldrich, St. Louis, MO, USA). Simultaneously, a positive control of ascorbic acid (Sigma-Aldrich, St. Louis, MO, USA) was also tested. Scavenging activity (%) was calculated as the change in the absorbance of the mixture (DPPH + fungal crude extract) with respect to the DPPH solution only (control).
Anticancer activity Cytotoxicity was evaluated against human breast (MCF-7) adenocarcinoma by the sulforhodamine B (SRB) assay according to Skehan et al. (1990). 100 μL of the cell suspension (5 × 103 cells) were transferred into 96-well plates then incubated for 24 h in complete media. These cells were treated with another 100 μL media containing the fungal extract. Cells were fixed after 72 h of exposure by replacing media with 10% Trichloroacetic acid (150 μL) and incubated for 1 h at 4 °C. The trichloroacetic acid solution was removed and the cells were washed 5 times with sterile deionized water. Then, 70 μL of 0.4%, w/v SRB solution was added and darkly-incubated for 10 min at room temperature. Plates were washed thrice with 1% acetic acid and let to air-dry overnight. Finally, 150 μL of TRIS (10 mM) solution was added to dissolve protein-bound SRB stain and the absorbance was measured at 540 nm (BMG LABTECH®-FLUOstar Omega microplate reader, Ortenberg, Germany). Cell viabilities was determined by the following equation:
% of Viability = [Absorbance of treated cells / Absorbance of control cells] × 100.
Fungal strains
Sixty-nine endophytic fungal isolates were screened for their bioactivity (as described earlier). Among the isolated fungi, methylene chloride extracts of two different isolates were found to have antifungal, antibacterial, anticancer, antioxidant activities. These strains were Aspergillus sydowii isolated from the bark of Ricinus communis and Aspergillus flavus isolated from the twigs of Psidium guajava. The two respective strains were identified and deposited under numbers AUMC14506 and AUMC14507 in the Culture Collection (aun.edu.eg/aumc/aumc.htm) of Assiut University Mycological Center, Egypt.
Identification of the selected endophytic fungi
Identification of the two strains was accomplished by colony morphology, growth characteristics, and molecular characterization. Morphological identification was performed by studying the colony on Czapek's-yeast autolysate agar according to Moubasher (1993). Czapek's-yeast autolysate agar composition (g L−1) as follows yeast extract 5, NaNO3 3, sucrose 3, MgSO4.7H2O 0.5, KH2PO4 0.5, KCl 0.5, and FeSO4.7H2O 0.01.
Molecular characterization was performed according to the method by White et al. (1990) using PCR-amplified ITS1-5.8S-ITS2 rRNA-gene. In brief, DNA of the fungal strains were extracted and sequenced by Solgent Company (Daejeon, South Korea). Sequences of the two strains were submitted to the GenBank and accession numbers were received. Finally, sequences were analyzed using the online tool (http://www.ncbi.nlm.nih.gov/) BLAST and the software BioEdit (version 7.0.1). A neighbor-joining tree with the maximum-likelihood for each fungal strain were constructed using MEGA software version 6.0.
GC–MS analysis of the fungal extracts:
The methanolic extracts from the two fungal strains were analyzed using a Thermo Scientific, Trace GC Ultra/ISQ Single Quadrupole MS, TG-5MS fused silica capillary column (30 m, 0.251 mm, 0.1 mm film thickness). An electron ionization system (ionization energy of 70 eV) and Helium as the carrier gas (at a constant flow rate of 1 mL min−1) were used. The MS transfer line and the injector temperature were set at 280 ℃. Identification of all the compounds was performed by the comparison of their mass spectra and relative retention time with those of the NIST, WILLY library data of the GC–MS system.
Influence of several 60Co gamma irradiation doses on the antifungal, antibacterial, anticancer, antioxidant activities
Spore suspensions of Aspergillus sydowii and Aspergillus flavus were prepared as described earlier. The two suspensions were separately irradiated by 250, 500, 1000, 2000 and 4000 Gy of gamma rays. A 60Co Gamma chamber, MC20, Russia (dose rate of 432.80 Gy h−1) was used. After irradiation, suspensions of each irradiation dose were kept in darkness overnight. An aliquot of 1 mL of each suspension was inoculated to 250-mL Erlenmeyer flasks (containing 50-mL potato-dextrose broth adjusted to pH 6.0) and incubated at 30 °C. Finally, fungal cultures corresponding to every irradiation dose were extracted concentrated according to the previous procedures. The antifungal, antibacterial, anticancer, antioxidant activities were estimated from each radiation dose, as described earlier.
Statistics
The recorded results were expressed as the mean taken from triplicate measurements from three independent experiment ± the standard deviation. Statistical significance was studied by the ANOVA-test followed by Dunken’s test using as SPSS software (v. 22, IBM, NY) at 95% confidence intervals.
Results
Isolation and screening of potential fungal endophytes
Eleven different plant species were used to isolate endophytic fungi (Table 1) from different plant parts including twigs, leaves, and bark. A total of 69 fungal isolates were recovered from the plant samples on PD agar plates. The isolated endophytes were subjected to a preliminary morphological examination to identify their genera. Consequently, eight genera were recorded including Aspergillus, Acremonium, Cladosporium, Trichoderma, Fusarium, Lasiodiplodia, and Alteranria.
The 69 isolates were separately cultured in potato-dextrose broth for 7 days at 30℃ then the culture broth was extracted. All the crude extracts from the isolated fungi were separately tested for their antifungal (against A. brasiliensis and C. albicans), antibacterial (against S. aureus and E. coli), anticancer (against MCF-7 human breast cancer), and antioxidant activities. Screening profile of the 69 isolates presented in Table 1 revealed that 12 strains showed varied activities. Among the 11 strains, only two strains were positive regarding all the tested activities. The two isolates showed all the tested bioactivates of antibacterial (Fig. 1a, b), antifungal (Fig. 1c, d), anticancer (Fig. 2), and antioxidant. Accordingly, the two fungal isolates were selected for further identification and chromatographic characterization of their extracts.
Fig. 1.
Photographs of the antimicrobial activity of A. sydowii AUMC14506 and A. flavus AUMC14507 crude extracts against E. coli (A), S. aureus (B), A. brasiliensis (C), and C. albicans (D)
Fig. 2.

Photograph of the cytotoxic activity of A. sydowii AUMC14506 and A. flavus AUMC14507 crude extracts against human breast adenocarcinoma. A Control cancer cells, B Cells treated with extract of A. sydowii, and C, Cells treated with extract of A. flavus
Morphological and molecular characterization
Figure 3 showed the colony morphology of Aspergillus sydowii AUMC14506 grown on CYA-agar plates. The strain had a bluish green velutinous restricted colony in the right view at 25 °C after 10 days (Fig. 3A). Meanwhile, the reverse view showed a pale to orange brown color (Fig. 3B). Microscopic appearance showed vesicles, metulae, phialides and globose conidia (Fig. 3C, D). The sequence obtained from molecular characterization was deposited under the number MW092906 in the GenBank, then analyzed and a phylogenetic tree was developed. The obtained data (Fig. 3E) confirmed that A. sydowii AUMC14506 showed 99.47—100% identity with several strains of A. sydowii including the type strain CBS593.65 T. Strains of A. nidulans are included as outgroup species in the phylogenetic tree.
Fig. 3.
Morphological and molecular characteristics of A. sydowii AUMC14506. Colony growth was observed on Czapek Yeast autolystae agar after incubation for 10 days at 25 °C (A, B). Microscopic appearance of conidia and conidiophore (C, D). Phylogenetic tree of the fungal isolate (AUMC14506) and other closely related strains of A. sydowii, based on the ITS1-5.8S rRNA-ITS2 rDNA sequences (E)
Figure 4 showed the colony morphology of Aspergillus flavus AUMC14507 grown on CYA-agar plates. The strain had a yellow green colony in the right view at 25 °C after 10 days (Fig. 4A). Meanwhile, microscopic appearance presented conidial head showing vesicle, metulae, phialides and rough-walled conidia (Fig. 4B). The sequence obtained from molecular characterization was deposited under the number MW092907 in the GenBank, then analyzed and a phylogenetic tree was developed. The obtained data (Fig. 4C) confirmed that A. flavus AUMC14507 showed 99.63%—100% identity with several strains of A. flavus including the Type strain ATCC16883T. Strains of A. nidulans are included as outgroup species in the phylogenetic tree.
Fig. 4.
Morphological and molecular characteristics of A. flavus AUMC14507. Colony growth was observed on Czapek Yeast autolystae agar after incubation for 10 days at 25 °C (A). Microscopic appearance of conidia and conidiophore (B). Phylogenetic tree of the fungal isolate (AUMC14507) and other closely related strains of A. sydowii, based on the ITS1-5.8S rRNA-ITS2 rDNA sequences (C)
Identification of chemical constituents of the fungal extracts by GC–MS
GC–MS analysis of the crude extracts of the Aspergillus sydowii AUMC14506 and Aspergillus flavus AUMC14507 revealed the presence of a wide array of compounds. The total peaks area of the detected compounds, the retention time, molecular weight, molecular formula, and structures of the detected compounds present in extracts are listed in Table 2 (for A. sydowii) and Table 3 (for A. flavus). The chromatograms are shown in Fig. 5 (5A, for A. sydowii) and (5B, for A. flavus). Forty compounds (1.00 to 9.00% percent peak area) were identified in fungal extract of A. sydowii (Table 2) where the major compounds were 9-Octadecenoicacid methyl ester (19.00%), ( +)-(1 s,2 s)-(2-phenylcyclopropyl) methanol (7.07%), Hexadecanoic acid,methyl ester (4.05%), 1-(3-Isobutyryl -bicyclo[1.1.1]pent-1-yl-)-2-methylpropan-1-one (3.62%), and 4,5,6,6a,10′,11-′hexahydrospiro{5′H-dibenzo[a,d]cycloheptene-5′,3(3aH)-[4,5,6]methenocyclopentapyrazole}(3.56%). Meanwhile, a total of forty compounds (1.05 to 18.08% percent peak area) were identified in A. flavus extract (Table 3) where the major compounds were 29-Octadecenoicacid,methyl ester, (E)-(CAS) (18.08%), Hexadecanoic acid, methyl ester (10.18%), 9,12-Octadecadienoic acid, methyl ester, (E,E)-(CAS) (4.90%) and 3,4-Dihydro-2H-1,5(3″-t-butyl) Benzodioxepine (4.12%).
Table 2.
GC–MS analysis of the methylene chloride extract of A. sydowii AUMC14506
| No | RT (min( |
MW | MF | Area (%) |
Detected compounds | Bioactivity | Reference |
|---|---|---|---|---|---|---|---|
| 1 | 5.08 | 148 | C10H12O | 7.07 | ( +)-(1 s,2 s)-(2-phenylcyclopropyl) methanol | Antimicrobial | Bisht et al. (2010) |
| 2 | 6.16 | 649 | C32H19Cl4N3O4 | 1.20 | 4,5,6,7-Tetrakis(p-chlorophenoxy) 1,2-diiminoisoin Doline | Antitumor | Ol´shevskaya et al. (2014) |
| 3 | 7.31 | 129 | C8H19N | 1.41 | 1-Butanamine,N-butyl-(CAS) | ||
| 4 | 9.93 | 44 | C2H4O | 1.06 | Oxirane (CAS) | Antimicrobial, Anticancer | Thirunarayanan and Vanangamudi (2011) |
| 5 | 12.68 | 648 | C44H56O4 | 1.43 | 5,11,17,23-Tetra-t-butyl-25,26,27,28-tetrahydroxycalix-4-arene | Antimicrobial | Muneer et al. (2016) |
| 6 | 12.94 | 692 | C44H44N4O4 | 1.09 | N,N′-Dicyclohexyl-1,7-dipyrrolidinylperylene-3,4:9,10-tetracarboxylic acid bisimide | ||
| 7 | 13.09 | 692 | C45H32N4O4 | 1.06 | 8-Oxo-5,6-dihydro-6-(methoxycarbonyl)-5,10,15,20-tetraphenyl-8H-7- oxaprphyrin | ||
| 8 | 16.26 | 678 | C45H58O5 | 1.17 | 7,13,19,25-Tetra-tert-butyl-27,28,29,30-tetrahydroxy-2,3-bishomo-3-oxacalix[4]arene | Antimicrobial | Muneer et al. (2016) |
| 9 | 16.57 | 640 | C45H36O4 | 1.10 | 5,10,10,11Tetra(4-methoxypheny)-10H-benzo[b]fluorene | ||
| 10 | 17.14 | 649 | C32H19Cl4N3O4 | 1.35 | 4,5,6,7-Tetrakis(p-chlorophenoxy)-1,2-diiminoisoindoline | Antitumor | Ol´shevskaya et al. (2014) |
| 11 | 20.35 | 626 | C40H34N8 | 1.76 | Tetraethyl-phthalocyanine | Antitumor | Boyle et al. (1993) |
| 12 | 20.53 | 208 | C13H20O2 | 3.62 | 1-(3-Isobutyryl -bicyclo[1.1.1]pent-1-yl-)-2-methylpropan-1-one | ||
| 13 | 21.19 | 152 | C10H16O | 2.17 | à-methyl-à-(2-propenyl)-1-cyclopentene-1-methanol | Antimicrobial | Bisht et al (2010) |
| 14 | 21.98 | 102 | C5H10O2 | 2.51 | 2- Furanmethanol,tetrahydro-(CAS) | ||
| 15 | 22.34 | 298 | C21H18N2 | 3.56 |
4,5,6,6a,10′,11-'hexahydrospiro{5′H-dibenzo[a,d]cycloheptene- 5′,3(3aH)-[4,5,6]methenocyclopentapyrazole} |
||
| 16 | 27.43 | 539 | C35H57NO3 | 1.12 | N-Butyl,N-methyl-11-(3′-methoxy-17′á-hydroxy-1′,3′,5′(10′)-estratrien-15′(à,beta.)-yl)undecanamide | ||
| 17 | 27.63 | 661 | C45H63N3O | 1.32 | Myrmicarin 661 | Pharmacological | Snyder et al. (2010) |
| 18 | 30.90 | 270 | C17H34O2 | 4.05 | Hexadecanoic acid,methyl ester (CAS) | Antibacterial | Astiti and Ramona (2021) |
| 19 | 34.03 | 678 | C40H46N4O6 | 2.20 | 2,3-diethyl-6,7-bis(2-methoxycarbonylethyl)-ç-(2-methoxycarbonylvinyl)-1,4,5,8-tetramethylporphyrin | Antibacterial | Sułek et al. (2020) |
| 20 | 34.13 | 296 | C19H36O2 | 19.0 | 9-Octadecenoicacid,methyl ester, (E)-(CAS) | Anticancer | Ahamed et al. (2020) |
| 21 | 34.58 | 298 | C19H38O2 | 1.30 | Octadecanoic acid,methyl ester (CAS) | Cytotoxic | Atasever-Arslan et al. (2015) |
| 22 | 37.14 | 694 | C48H62N4 | 1.74 | 2,7,12,17-Tetraethyl-3,5:8,10:13,15:18,20-tetrakis (2,2-dimethylpropano) porphyrin | Antibacterial | Amos-Tautua et al. (2020) |
| 23 | 46.74 | 606 | C36H38O5 | 1.06 | Methyl phaeophorbide-a | Antioxidant | Yoon et al. (2011) |
| 24 | 47.15 | 692 | C44H44N4O4 | 1.05 | N,N′-Dicyclohexyl-1,7-dipyrrolidinylperylene-3,4:9,10- tetracarboxylic acid bisimide | ||
| 25 | 47.88 | 661 | C45H63N3O | 1.09 | Myrmicarin 661 | Pharmacological | Snyder et al (2010) |
| 26 | 48.18 | 669 | C41H29Cl2NO4 | 1.00 | 2,4-Di(4-chlorobenzoyl)3,5-diphenyl-6-(4- methoxyphenyl) aniline acetanilide | ||
| 27 | 48.28 | 633 | C37H44ClNO6 | 1. 20 | PENITREM A |
Anticancer Antimicrobial |
Sallam et al. (2013) Amos-Tautua et al. (2020) |
| 28 | 48.76 | 648 | C35H38Cl2N4O4 | 1.29 |
2,4bis-(á-chloroethyl)-6,7-bis[ámethoxycarbonylethyl]-1,3,5- trimethylporphyrin |
||
| 29 | 49.08 | 611 | C38H33N3O5 | 1.01 | N-Cyclohexyl-1,7-dipyrrolidinylperylene-3,4:9,10-tetracarboxylicacid3,4-anhydride-9,10-imide | ||
| 30 | 49.47 | 277 | C19H35N | 1.04 | 3,5Bis(cyclohexylmethyl)piperidine | Antioxidant | Manjusha et al. (2018) |
| 31 | 49.65 | 603 | C33H46ClNO7 | 1.32 | Milbemycin b,13-chloro-5-demethoxy-28-deoxy-6,28-epoxy -5-(hydroxyimino)-25-(1-methylethyl)-,(6R,13R,25R)- | ||
| 32 | 51.41 | 711 | C43H37NO9 | 1.85 |
3,6-Diphenyl-3,6-(hydroxyimino)-4,5-(2,2'-diphenylene) tricyclo [6.2.1.0(2,7)]undeca-3,5-diene-9,10-(E)-dicarboxylic Acid diacetoxy methyl ester |
||
| 33 | 51.93 | 678 | C45H58O5 | 1.37 | 7,13,19,25-Tetra-tert-butyl-27,28,29,30-tetrahydroxy-2,3-bishomo-3-oxacalix[4]arene | ||
| 34 | 52.22 | 660 | C20Cl12 | 1.16 | Dodecachloroperylene | ||
| 35 | 52.73 | 616 | C32H40O12 | 1.21 | Anodendroside E 2,monoacetate | Antimicrobial | Abdel-Rahman et al. (2019) |
| 36 | 52.80 | 616 | C32H40O12 | 1.73 | Anodendroside E 2,Monoacetate | Antimicrobial | Abdel-Rahman et al. (2019) |
| 37 | 53.28 | 536 | C28H40O10 | 1.29 | 9-Desoxo-9-xacetoxy-3,8,12-tri-O-acetylingol | Antibacterial | Shareef et al. (2016) |
| 38 | 53.39 | 694 | C48H62N4 | 1.59 | 2,7,12,17-Tetraethyl-3,5:8,10:13,15:18,20-tetrakis(2,2-dimethylpropano) Porphyrin | Antibacterial | Sułek et al. (2020 |
| 39 | 54.67 | 542 | C40H62 | 1.37 | Phytofluene | Antimicrobial | Engelmann et al. (2011) |
| 40 | 54.95 | 582 | C30H42N6O6 | 1.28 | 2,4,6-Tris(1-(2-methoxyc arbonylpyrrolidin-1-yl)propen-2-yl)-1,3,5-triazine | Antiinfammatory | El-Reedy and soliman (2020) |
Table 3.
GC–MS analysis of the methylene chloride extract of A. flavus AUMC14507
| No | RT (min( |
MW | MF | Area (%) |
Detected compounds | Bioactivity | Reference |
|---|---|---|---|---|---|---|---|
| 1 | 5.05 | 324 | C19H20N2O3 | 4.63 | 20-Deethyl-17-oxovincadifformine | Cytotoxic, Antimicrobial | Zhang et al. (2014) |
| 2 | 5.23 | 129 | C8H19N | 1.22 | N,N-Bis (isobutyl)amine |
Antitumor, Antimicrobial, |
Kumar et al. (2018) |
| 3 | 5.30 | 116 | C5H8O3 | 1.44 | ( +)-(S)-5-Hydroxymethyloxolan-2-one | ||
| 4 | 6.43 | 84 | C4H8N2 | 1.10 | Acetonitrile, (dimethylamino)- (CAS) | ||
| 5 | 10.37 | 386 | C18H15ClN4O4 | 1.13 | 3-(p-Ethoxyphenyl)-4-[5-(2-chlorophenyl)-dealta.(2)-1,2,4-oxadiazolin-3-yl]sydnone | Antimicrobial | Mallur and Badami (2000) |
| 6 | 10.65 | 572 | C37H32O6 | 1.05 | (-)-2,2′,3,3′-Tetraethyl-(8-hydroxy-8-methoxy)-7,7′-bi(phenanthrene-1,4-dione) | Cytotoxicity, Antimicrobial | Kovács's et al. (2008) |
| 7 | 15.94 | 696 | C51H68O | 1.11 | Bis(3,6-di-tert-butyl-1-azulenyl)(3,5-ditert-butyl-4-hydroxyphenyl)methane | Antibacterial, Antioxidant | Praveen et al. (2015) |
| 8 | 16.86 | 692 | C44H44N4O4 | 1.19 | N,N-'Dicyclohexyl-1,7-dipyrrolidinylperylene-3,4:9,10-tetracarboxylicacidbisimide | ||
| 9 | 17.87 | 658 | C44H42N4O2 | 1.10 | 2,9-Bis(5-tert-butyl-2-methoxy-3-pyridylphenyl)-1,10-phenanthroline | ||
| 10 | 17.94 | 696 | C40H56O10 | 1.24 | Nephthoside -1,2′,3′,4′-Tetraacetate | ||
| 11 | 18.52 | 656 | C36H52N2O9 | 1.57 | Jiufengdine | Drug lead | Zhou et al. (2004) |
| 12 | 19.40 | 698 | C48H34N4O2 | 1.65 | Cis-5,10-bis(4-formylphenyl)-15,20-di(4′′-tolyl) porphyrine | Photodynamic therapy of tumor | Lamarche and Francois (2002) |
| 13 | 21.17 | 659 | C34H45NO12 | 1.10 | 3-Acetoy-8-deacetoxy-N,19-seco-22-nor-17-(1,2-oxazocyclopropan-1-yl) yunaconitine | Antiinfammatory, Antineoplastic | Zhang et al. (2020) |
| 14 | 22.00 | 760 | C48H56O8 | 1.37 | Methoxychromene precocene tetramer | ||
| 15 | 22.05 | 58 | C4H10 | 1.81 | Butane (CAS) | ||
| 16 | 22.34 | 206 | C13H18O2 | 4.12 | 3,4-Dihydro-2H-1,5(3′′-t-butyl) Benzodioxepine | Antioxidant | Zhang et al. (2014) |
| 17 | 22.86 | 666 | C26H16Cl6O8 | 1.11 | Russuphelol | Cytotoixic | Laus (2001) |
| 18 | 24.48 | 636 | C18Cl12 | 1.06 | Dodecachloro-3,4-benzo Phenanthrene | Anticancer | Li et al. (2006) |
| 19 | 26.43 | 60 | C8H17NO | 1.40 | 2-[N-(tButylamino)]-2-methylpropanal | ||
| 20 | 26.68 | 618 | C39H54O6 | 1.24 | 2-Hydroxy-3-methoxy-6,7,10,11-tetrapentyloxytriphenylene | ||
| 21 | 30.89 | 270 | C17H34O2 | 10.18 | Hexadecanoic acid, methyl ester (CAS) | Antibacterial | Astiti and Ramona (2021) |
| 22 | 31.62 | 678 | C36H40Cl2N4O5 | 1.08 | 2,4-bis(2-chloroethyl)-8-h ydroxymethyl)-6,7-bis[2-(methoxycarbonyl) ethyl]-1,3,5-trimethylporphyrin | Photodynamic therapy of tumor | Lamarche et al. (2002) |
| 23 | 32.77 | 111 | C5H5NO2 | 1.06 | 3-Deazauracil | Antiviral,Anticancer | Ogilvie et al. (1984) |
| 24 | 34.03 | 294 | C19H34O2 | 4.90 | 9,12-Octadecadienoic acid, methyl ester, (E,E)-(CAS) | ||
| 25 | 34.12 | 296 | C19H36O2 | 18.08 | 9-Octadecenoicacid,methyl ester, (E)-(CAS) | Anticancer | Ahamed et al. (2020) |
| 26 | 34.58 | 340 | C22H44O2 | 3.04 | Heneicosanoic acid, methyl ester (CAS) | Antimicrobial Antioxidant | Salem et al. (2014) |
| 27 | 38.46 | 729 | C37H47NO14 | 1.13 | N-De-ethylyunaconitineimine N-oxide | ||
| 28 | 39.12 | 670 | C48H38N4 | 1.05 | 2-Butyl-5,10,15,20- tetraphenylporphyrin | ||
| 29 | 41.07 | 486 | C27H38N2O6 | 1.37 | 4,25-Secoobscurinervan4-ol,25-ethyl-15,16-dimethoxy-,25 acetate,(4á,22à)- | ||
| 30 | 41.65 | 144 | C9H20O | 1.34 | 3-Ethyl-2-heptanol | ||
| 31 | 42.06 | 126 | C7H14N2 | 1.07 | 6-Cyanohexanamine | ||
| 32 | 42.14 | 378 | C22H22N2O4 | 1.12 | Isopropyl4,6-dioxo-3,5-diphenyl-perhydropyrrolo[3,4-c] Pyrrole-1-carboxylate | ||
| 33 | 42.40 | 696 | C40H56O10 | 1.18 | Nephthoside -1,2′,3′,4′-Tetraacetate |
Cytotoxic Antioxidant |
Sunassee and Davies-Coleman (2012) |
| 34 | 42.59 | 692 | C44H44N4O4 | 1.12 | N,N′-Dicyclohexyl-1,7-dipyrrolidinylperylene-3,4:9,10-tetracarboxylic acid bisimide | ||
| 35 | 43.18 | 616 | C32H40O12 | 1.06 | Anodendroside E 2,monoacetate | Antimicrobial | Abdel-Rahman et al. (2019) |
| 36 | 44.41 | 633 | C37H44ClNO6 | 1.21 | PENITREM A |
Antimicrobial Anticancer |
Sallam et al. (2013) Amos-Tautua et al. (2020) |
| 37 | 44.75 | 692 | C44H44N4O4 | 1.15 | N,N′ –Dicyclohexyl-1,7-dipYrrolidinylperylene-3,4:9,10-tetracarboxylic acid bisimide | ||
| 38 | 47.81 | 676 | C36H60N4O8 | 1.04 | Bis(3,6,9,12-tetraoxapentaethylene)crowno-N,N,N′,N′-tetramethyl-p- phanediamine | ||
| 39 | 53.65 | 489 | C27H39NO7 | 1.69 | 3-Acetoxy-8,9-dehydro-12,13-secopseudaconin-14-one | ||
| 40 | 54.32 | 660 | C32H40O12 | 1.61 | Anodendroside E 2,monoacetate (CAS) | Antimicrobial | Abdel-Rahman et al. (2019) |
Fig. 5.
GC–MS chromatograms of crude extracts from fungal culture of A. sydowii (A) and A. flavus (B). The methylene chloride extracts were evaporated and dissolved in 1 mL of HPLC-grade methanol and used under the conditions described in “Materials and methods” section
Improving the antifungal, antibacterial, cytotoxic, and antioxidant potentials A. sydowii and A. flavus by gamma irradiation
Several gamma irradiation doses ranged from 250 to 4000 Gy used to study their effects on enhancing bioactivities of A. sydowii and A. flavus. Generally, remarkable feature of the obtained results is the dose-related behavior of the influence of gamma irradiation on the recorded activities either antimicrobial (Tables 4 and 5), antioxidant, or anticancer (Table 6) for both strains. The recorded data on the estimated bioactivities further indicated that 1000 Gy was the most proper dose for attaining the highest rates of the antifungal, antibacterial, anticancer and antioxidant activities for both strains. When compared to the control (non-irradiated), significant differences (P ≤ 0.05) in the recorded values were observed for both strains in all the measured activities (Tables 4, 5, and 6).
Table 4.
Effect of different doses of gamma irradiation on the antifungal activity (expressed as diameter of inhibition zone in mm) of A. sydowii AUMC14506 and A. flavus AUMC14507
| Gamma irradiation dose | A. sydowii AUMC14506 | A. flavus AUMC14507 | ||
|---|---|---|---|---|
| (Gy) | A. brasiliensis | C. albicans | A. brasiliensis | C. albicans |
| 0.00 (C) | 14.33 ± 0.00 cd | 18.00 ± 1.00c | 12.67 ± 2.08c | 16.33 ± 0.58 c |
| 250 | 16.67 ± 1.06 cd | 20.00 ± 1.66c | 14.33 ± 1.66c | 18.33 ± 2.05c |
| 500 | 22.33 ± 1.52b | 25.67 ± 1.66b | 20.00 ± 0.58b | 24.88 ± 1.15b |
| 1000 | 28.33 ± 1.77a | 31.33 ± 2.56a | 26.33 ± 1.54a | 29.00 ± 2.57a |
| 2000 | 11.67 ± 1.66d | 12.33 ± 1.78d | 10.00 ± 1.00c | 10.57 ± 1.15d |
| 4000 | 0.00e | 0.00e | 0.00d | 0.00e |
Calculated mean is for triplicate measurements from two independent experiments ± SD
a−e means with different superscripts in the same column for each nanoparticle are considered statistically different (LSD test, P ≤ 0.05)
Table 5.
Effect of different doses of gamma irradiation on the antibacterial activity (expressed as diameter of inhibition zone in mm) of A. sydowii AUMC14506 and A. flavus AUMC14507
| Gamma irradiation dose | A. sydowii AUMC14506 | A. flavus AUMC14507 | ||
|---|---|---|---|---|
| (Gy) | E. coli | S. aureus | E. coli | S. aureus |
| 0.00 (C) | 18.33 ± 1.53c | 16.33 ± 1.00c | 17.33 ± 0.58c | 15.67 ± 1.67c |
| 250 | 20.67 ± 0.58c | 18.67 ± 1.67c | 19.33 ± 1.58c | 19.67 ± 2.05c |
| 500 | 25.33 ± 1.53b | 25.67 ± 1.05b | 25.00 ± 1.00b | 26.33 ± 0.58b |
| 1000 | 34.00 ± 1.00a | 33.67 ± 2.56a | 31.67 ± 2.05a | 32.67 ± 2.57a |
| 2000 | 12.33 ± 0.58d | 11.00 ± 1.78d | 12.00 ± 1.00d | 11.33 ± 1.06d |
| 4000 | 0.00e | 0.00e | 0.00e | 0.00e |
Calculated mean is for triplicate measurements from two independent experiments ± SD, a−e means with different superscripts in the same column for each nanoparticle are considered statistically different (LSD test, P ≤ 0.05)
Table 6.
Effect of different doses of gamma irradiation on the antioxidant (% of DPPH scavenging) and cytotoxic (% of viability) activities of A. sydowii AUMC14506 and A. flavus AUMC14507
| Gamma irradiation dose | DPPH scavenging (%) | Viability (%) | ||
|---|---|---|---|---|
| (Gy) | AUMC14506 | AUMC14507 | AUMC14506 | AUMC14507 |
| 0.00 (C) | 14.65 ± 1.32d | 13.87 ± 1.78d | 31.55 ± 1.32b | 40.87 ± 1.11b |
| 250 | 22.55 ± 1.87c | 22.52 ± 1.03c | 28.01 ± 1.74c | 36.41 ± 1.86c |
| 500 | 28.09 ± 2.11b | 27.89 ± 2.43b | 14.99 ± 2.06d | 22.87 ± 4.11d |
| 1000 | 53.67 ± 3.65a | 48.87 ± 2.11a | 09.96 ± 0.41e | 09.41 ± 5.92e |
| 2000 | 10.55 ± 1.83d | 11.06 ± 1.01d | 45.57 ± 2.33a | 43.05 ± 1.23a |
| 4000 | 0.00e | 0.00e | 0.00f | 0.00f |
Calculated mean is for triplicate measurements from two independent experiments ± SD, a−f means with different superscripts in the same column for each nanoparticle are considered statistically different (LSD test, P ≤ 0.05)
Discussion
Endophytic fungi are currently suggested as the most promising sources for new metabolites (El-Sayed 2021) with diverse range of bioactivities that will surely open the way for several medical, agricultural, and industrial applications. In this context, metabolites derived from fungal endophytes are gaining considerable attention to be used as novel antimicrobial agents. Thus, the aim of this study lies in an even less understood research area with significant unexploited potential: bioactive metabolites from fungal endophytes of some certain plants in Egypt. As a first step, 69 endophytic strains were isolated from eleven different plant species. The isolated endophytes were found to belong to eight genera as follows: Aspergillus, Acremonium, Cladosporium, Trichoderma, Lasiodiplodia, Fusarium, and Alteranria. The isolated strains were then cultivated in PDA plates and PD broth (pH 6.0), then extracted and tested for their antifungal (against C. albicans and A. brasiliensis), antibacterial (S. aureus and E. coli), cytotoxic (against MCF-7 breast cancer cell lines), and free DPPH-scavenging potentials. The screening profile of the fungal extracts revealed that 12 fungal strains shown bioactive potential with vary degrees. Surprisingly, two fungal strains, amongst the 69 strains, displayed all the tested activities of antifungal, antibacterial, cytotoxic, and antioxidant potentials, thus they were selected. Morphological examination of the two fungal strains maintained on the CYA agar (grown at 25 °C for 10 days) were identical with the characteristics concerning the identification of A. sydowii and A. flavus (Moubasher 1993). As such, data obtained from the molecular studies of these strains confirmed the high conformity with their closely related fungi.
In this study, identification of chemical constituents of the methanolic extracts of the two fungal strains was accomplished by GC–MS. The obtained results confirmed presence of several well-known bioactive compounds produced by the two fungal strains. In fungal extract of A. sydowii, the major compounds were 9-Octadecenoicacid methyl ester (Anticancer, Ahamed et al. 2020), ( +)-(1 s,2 s)-(2-phenylcyclopropyl) methanol (Antimicrobial, Bisht et al. 2010), Hexadecanoic acid,methyl ester (Antimicrobial, Astiti and Ramona 2021), 1-(3-Isobutyryl -bicyclo[1.1.1]pent-1-yl-)-2-methylpropan-1-one (unreported), and 4,5,6,6a,10′,11-′hexahydrospiro{5′H-dibenzo[a,d]cycloheptene-5′,3(3aH)-[4,5,6]methenocyclopentapyrazole}. Moreover, several bioactive compounds were detected in smaller amounts. Table 2 presented all the reported compounds and their bioactivity. Meanwhile, A. flavus extract showed major compounds of 9-Octadecenoicacid,methyl ester, (E)-(CAS) (Anticancer, Ahamed et al. 2020), Hexadecanoic acid, methyl ester (Antimicrobial, Astiti and Ramona 2021), 9,12-Octadecadienoic acid, methyl ester, (E,E)-(CAS) (Anticancer, Ahamed et al. 2020), and 3,4-Dihydro-2H-1,5(3″-t-butyl) Benzodioxepine (Antioxidant, Zhang et al. 2014). Moreover, several bioactive compounds were detected in smaller amounts. Table 3 presented all the reported compounds and their bioactivity.
Here, the presented study was extended to evaluate the use of gamma irradiation for improving the achieved bioactivities of A. sydowii and A. flavus. Our results confirmed the positive role of gamma rays at 1000 Gy for achieving the highest values of the antifungal, antibacterial, cytotoxic, and antioxidant activities for both strains. In agreement with these results, the same dose of gamma rays (1000 Gy) was used for improving titers of the cardiac glycoside digoxin produced by Epicoccum nigrum (El-Sayed et al. 2020c) with a recorded five-fold increase higher than the control cultures. Moreover, the most 500 Gy of gamma rays was used for maximum production of the acetylcholinesterase inhibitor HupA from A. brassicae cultures (Zaki and El-Sayed 2021). Also, titers of the anticancer drug taxol was successfully intensified following gamma radiation of Alternaria tenuissima and Aspergillus fumigatus at 750 Gy (El-Sayed et al. 2019b, 2019c). In another connection, lower doses of gamma rays (5–250 Gy) Alternaria tenuissima cultures to improve the yield of sugars and proteins from (Geweely and Nawar 2006). Generally, gamma radiation is a powerful energetic ionizing radiation (El-Sayed et al. 2019a; 2020a). Exposure of living cell to this type of radiation at certain doses can initiate mutations through several mechanisms such as the DNA repair of genes (El-Sayed et al. 2020b; d). Most recently, mutagenesis by gamma rays was highly recommended in this regard to improve the target microbial strains thereby intensifying their producing capabilities (El-Sayed et al. 2020e, f; Zaki et al. 2020; and references therein).
In summary, two promising endophytic fungal strains showed antifungal, antibacterial, cytotoxic, and antioxidant potentials. The strains were identified as Aspergillus sydowii AUMC14506 and A. flavus AUMC14507, based on morphological and molecular studies. Chemical constituents present in extracts of the two strains were identified by GC-Mass analyses. Morevover, all the achieved bioactivities of the two strains were significantly intensified using 1000 Gy gamma rays. These findings strongly recommend the bioprospection of endophytic fungi as promising sources of bioactive metabolites with antimicrobial, anticancer, and antioxidant potentials.
Acknowledgements
Not applicable.
Author contributions
ERE research topic suggestion, experimental methodology design, experimental, data analysis, original draft writing and manuscript revision. SRM experimental, data analysis, original draft writing. MAH, MMS, MMA, and AAK experimental methodology design, data analysis, and manuscript revision. All authors read and approved the final manuscript.
Funding
Open access funding provided by The Science, Technology & Innovation Funding Authority (STDF) in cooperation with The Egyptian Knowledge Bank (EKB). Not applicable.
Availability of data and materials
All data generated or analyzed during this study are included in this published article.
Declarations
Ethics approval and consent to participate
Not applicable.
Consent for publication
The authors of this article consented to its publication.
Competing interests
The authors declare no conflict of interests.
Footnotes
Publisher's Note
Springer Nature remains neutral with regard to jurisdictional claims in published maps and institutional affiliations.
References
- Abdel-Rahman T, Hussein AS, Beshir S, Hamed AR, Ali E, El-Tanany SS. Antimicrobial activity of terpenoids extracted from Annona muricata seeds and its endophytic Aspergillus niger Strain SH3 either singly or in combination. Open Access Maced J Med Sci. 2019;7:3127–3131. doi: 10.3889/oamjms.2019.793. [DOI] [PMC free article] [PubMed] [Google Scholar]
- Ahamed A, Panneerselvam A, Alaklabi A, Arif IA, Ambikapathy V, Thajuddin N. Molecular perspective and anticancer activity of medicinal plants. Saudi J Biol Sci. 2020;27:666–675. doi: 10.1016/j.sjbs.2019.11.043. [DOI] [PMC free article] [PubMed] [Google Scholar]
- Alvin A, Miller KI, Neilan BA. Exploring the potential of endophytes from medicinal plants as sources of antimycobacterial compounds. Microbiol Res. 2009;169:483–495. doi: 10.1016/j.micres.2013.12.009. [DOI] [PMC free article] [PubMed] [Google Scholar]
- Amos-Tautua BM, Songca SP, Oluwafemi OS. Application of porphyrins in antibacterial photodynamic therapy. Molecules. 2020;24:2–28. doi: 10.3390/molecules24132456. [DOI] [PMC free article] [PubMed] [Google Scholar]
- Astiti NPA, Ramona Y. GC-MS analysis of active and applicable compounds in methanol extract of sweet star fruit (Averrhoa carambola L.) leaves. HAYATI J Biosci. 2021;28:11–22. doi: 10.4308/hjb.28.1.12. [DOI] [Google Scholar]
- Atanasov AG, Zotchev SB, Dirsch VM, Supuran CT, the International Natural Product Sciences Taskforce Natural products in drug discovery: advances and opportunities. Nat Rev Drug Discov. 2021;20:200–216. doi: 10.1038/s41573-020-00114-z. [DOI] [PMC free article] [PubMed] [Google Scholar]
- Atasever-Arslan B, Yilancioglu K, Bekaroglu MG, Taskin E, Altinoz E, Cetiner S. Cytotoxic effect of extract from Dunaliellasalina against SH-SY5Y neuroblastoma cells. Gen Physiol Biophys. 2015;34:201–207. doi: 10.4149/gpb_2014034. [DOI] [PubMed] [Google Scholar]
- Baron NC, Rigobelo EC. Endophytic fungi: a tool for plant growth promotion and sustainable agriculture. Mycology. 2022;13:39–55. doi: 10.1080/21501203.2021.1945699. [DOI] [PMC free article] [PubMed] [Google Scholar]
- Bisht S, Dwivedi N, Chaturvedi V, Ananda N, Misra M, Sharma R, Kumar B, Dwivedi R, Singh S, Sinha SK, Gupta V, Mishra PR, Dwivedi AK, Tripathia RP. Synthesis and optimization of antitubercular activities in a series of 4-(aryloxy) phenyl cyclopropyl methanols. Eur J Med Chem. 2010;45:5965–5978. doi: 10.1016/j.ejmech.2010.09.063. [DOI] [PubMed] [Google Scholar]
- Boyle RW, Leznoff CC, van Lier JE. Biological activities of phthalocyanines–XVI. Tetrahydroxy- and tetraalkylhydroxy zinc phthalocyanines. Effect of alkyl chain length on in vitro and in vivo photodynamic activities. Br J Cancer. 1993;67:1177–1181. doi: 10.1038/bjc.1993.222. [DOI] [PMC free article] [PubMed] [Google Scholar]
- dos Santos IR, Abdel-Azeem AM, Mohesien MT, Piekutowska M, Sheir DH, da Silva LL, Castro CDS, Carvalho DDC, Bezerra JDP, Saad HA, Borges LL, Xavier-Santos S. Insights into the bioprospecting of the endophytic fungi of the medicinal plant Palicourea rigida Kunth (Rubiaceae): detailed biological activities. J Fungi. 2021;7:689. doi: 10.3390/jof7090689. [DOI] [PMC free article] [PubMed] [Google Scholar]
- El-Reedy AAM, Soliman NK. Synthesis, biological activity and molecular modeling study of novel 1,2,4-triazolo[4,3-b][1,2,4,5] tetrazines and 1,2,4-triazolo[4,3-b] [1,2,4]triazines. Sci Rep. 2020;10:6137. doi: 10.1038/s41598-020-62977-x. [DOI] [PMC free article] [PubMed] [Google Scholar]
- El-Sayed ER. Discovery of the anticancer drug vinblastine from the endophytic Alternaria alternata and yield improvement by gamma irradiation mutagenesis. J Appl Microbiol. 2021;131:2886–2898. doi: 10.1111/jam.15169. [DOI] [PubMed] [Google Scholar]
- El-Sayed ER, Ahmed AS, Ismaiel AA. Agro-industrial byproducts for production of the immunosuppressant mycophenolic acid by Penicillium roqueforti under solid-state fermentation: enhanced production by ultraviolet and gamma irradiation. Biocatal Agric Biotechnol. 2019;18:101015. doi: 10.1016/j.bcab.2019.01.053. [DOI] [Google Scholar]
- El-Sayed ER, Ismaiel AA, Ahmed AS, Hassan IA, Karam El-Din AA. Bioprocess optimization using response surface methodology for production of the anticancer drug paclitaxel by Aspergillus fumigatus and Alternaria tenuissima: enhanced production by ultraviolet and gamma irradiation. Biocatal Agric Biotechnol. 2019;18:100966. doi: 10.1016/j.bcab.2019.01.034. [DOI] [Google Scholar]
- El-Sayed ER, Ahmed AS, Hassan IA, Ismaiel AA, Karam El-Din AA. Strain improvement and immobilization technique for enhanced production of the anticancer drug paclitaxel by Aspergillus fumigatus and Alternaria tenuissima. Appl Microbiol Biotechnol. 2019;103:8923–8935. doi: 10.1007/s00253-019-10129-1. [DOI] [PubMed] [Google Scholar]
- El-Sayed ER, Abdelhakim HK, Ahmed AS. Solid–state fermentation for enhanced production of selenium nanoparticles by gamma–irradiated Monascus purpureus and their biological evaluation and photocatalytic activities. Bioproc Biosyst Eng. 2020;43:797–809. doi: 10.1007/s00449-019-02275-7. [DOI] [PubMed] [Google Scholar]
- El-Sayed ER, Abdelhakim HK, Zakaria Z. Extracellular biosynthesis of cobalt ferrite nanoparticles by Monascus purpureus and their antioxidant, anticancer and antimicrobial activities: yield enhancement by gamma irradiation. Mater Sci Eng C. 2020;107:110318. doi: 10.1016/j.msec.2019.110318. [DOI] [PubMed] [Google Scholar]
- El-Sayed ER, Ahmed AS, Abdelhakim HK. A novel source of the cardiac glycoside digoxin from the endophytic fungus Epicoccum nigrum: Isolation, characterization, production enhancement by gamma irradiation mutagenesis and anticancer activity evaluation. J Appl Microbiol. 2020;128:747–762. doi: 10.1011/JAM.14510. [DOI] [PubMed] [Google Scholar]
- El-Sayed ER, Zaki AG, Ahmed AS, Ismaiel AA. Production of the anticancer drug taxol by the endophytic fungus Epicoccum nigrum TXB502: enhanced production by gamma irradiation mutagenesis and immobilization technique. Appl Microbiol Biotechnol. 2020;104:6991–7003. doi: 10.1007/s00253020-10712-x. [DOI] [PubMed] [Google Scholar]
- El-Sayed ER, Ahmed AS, Al-Hagar OEA. Agro-industrial wastes for production of paclitaxel by irradiated Aspergillus fumigatus under solid-state fermentation. J Appl Microbiol. 2020;128:1427–1439. doi: 10.1111/jam.14574. [DOI] [PubMed] [Google Scholar]
- El-Sayed ER, Ahmed AS, Hassan IA, Ismaiel AA, Karam El-Din AA. Semi-continuous production of the anticancer drug taxol by Aspergillus fumigatus and Alternaria tenuissima immobilized in calcium alginate beads. Bioprocess Biosyst Eng. 2020;43:997–1008. doi: 10.1007/s00449-020-02295-8. [DOI] [PubMed] [Google Scholar]
- El-Sayed ER, Mousa SA, Abdou DAM, Abo El-Seoud MA, Elmehlawy AA, Mohamed SS. Exploiting the exceptional biosynthetic potency of the endophytic Aspergillus terreus in enhancing production of Co3O4, CuO, Fe3O4, NiO, and ZnO nanoparticles using bioprocess optimization and gamma irradiation. Saudi J Biol Sci. 2022 doi: 10.1016/j.sjbs.2021.12.019. [DOI] [PMC free article] [PubMed] [Google Scholar]
- Engelmann I, Griffon A, Tichit L, Montañana-Sanchis F, Wang G, Reinke V, Waterston RH, Hillier LDW, Ewbank JJ. A comprehensive analysis of gene expression changes provoked by bacterial and fungal infection in C.elegans. PLoS ONE. 2011;6:e19055. doi: 10.1371/journal.pone.0019055. [DOI] [PMC free article] [PubMed] [Google Scholar]
- Geweely NSI, Nawar LS. Sensitivity to gamma irradiation of post-harvest pathogens of pear. Int J Agric Biol. 2006;8:710–716. [Google Scholar]
- Janso JE, Carter GT. Biosynthetic potential of phylogenetically unique endophytic actinomycetes from tropical plants. Appl Environ Microbiol. 2010;76:13. doi: 10.1128/AEM.02959-09. [DOI] [PMC free article] [PubMed] [Google Scholar]
- Karthikeyan A, Joseph A, Nair BG. Promising bioactive compounds from the marine environment and their potential effects on various diseases. J Genet Eng Biotechnol. 2022;20:14. doi: 10.1186/s43141-021-00290-4. [DOI] [PMC free article] [PubMed] [Google Scholar]
- Kovács A, Vasas A, Hohmann J. Natural phenanthrenes and their biological activity. Phytochemistry. 2008;69:1084–1110. doi: 10.1016/j.phytochem.2007.12.005. [DOI] [PubMed] [Google Scholar]
- Kumar C, Mongolla P. Bioprospecting of endophytic fungi for bioactive compounds. In: Gehlot P, Singh J, editors. Fungi and their role in sustainable development: current perspectives. Singapore: Springer; 2018. [Google Scholar]
- Kumar V, Bhatt V, Kumar N. Chapter 9—amides from plants: structures and biological importance. Stud Nat Prod Chem. 2018;56:287–333. doi: 10.1016/B978-0-444-64058-1.00009-1. [DOI] [Google Scholar]
- Lamarche F, Sol V, Huang Y, Granet R, Guilloton M, Krausz P. Synthesis and biological evaluation of porphyrin-polyamine conjugates as potential agents in photodynamic therapy (PDT) J Porphyr Phthalocya. 2002;6:130–134. doi: 10.1142/S1088424602000178. [DOI] [Google Scholar]
- Laus G. Biological activities of natural halogen compounds. Stud Nat Prod Chem. 2001;25:757–809. doi: 10.1016/S1572-5995(01)80022-3. [DOI] [Google Scholar]
- Mallur SG, Badami BV. Transformation of the sydnone ring into oxadiazolinones. A convenient one-pot synthesis of 3-Aryl-5-methyl-1,3,4-oxadiazolin-2-ones from 3-Arylsydnones and their antimicrobial activity. Il Farmaco. 2000;55:65–67. doi: 10.1016/S0014-827X(99)00103-2. [DOI] [PubMed] [Google Scholar]
- Manjusha Rk, Begum S, Begum A, Bharathi K. Antioxidant potential of piperdine containing compounds—a short review. Asian J Pharm Clin Res. 2018;11:66–73. doi: 10.22159/ajpcr.2018.v11i8.26536. [DOI] [Google Scholar]
- Miethke M, Pieroni M, Weber T, Brönstrup M, Hammann P, Halby L, Arimondo PB, Glaser P, Aigle B, Bode HB, Moreira R, Li Y, Luzhetskyy A, Medema MA, Pernodet J, Stadler M, Tormo JR, Genilloud O, Truman AW, Weissman KJ, Takano E, Sabatini S, Stegmann E, Brötz-Oesterhelt H, Wohlleben W, Seemann M, Empting M, Hirsch AKH, Loretz B, Lehr C, Titz A, Herrmann J, Jaeger T, Alt S, Hesterkamp T, Winterhalter M, Schiefer A, Pfarr K, Hoerauf A, Graz H, Graz M, Lindvall M, Ramurthy S, Karlén A, van Dongen M, Petkovic H, Keller A, Peyrane F, Donadio S, Fraisse L, Piddock LJV, Gilbert IH, Moser HE, Müller R. Towards the sustainable discovery and development of new antibiotics. Nat Rev Chem. 2021;5:726–749. doi: 10.1038/s41570-021-00313-1. [DOI] [PubMed] [Google Scholar]
- Moubasher AH (1993) Soil fungi in Qatar and other Arab countries. The Centre for Scientific and Applied Research, Doha.
- Mousa SA, El-Sayed ER, Mohamed SS, Abo El-Seoud MA, Elmehlawy AA, Abdou DAM. Novel mycosynthesis of Co3O4, CuO, Fe3O4, NiO, and ZnO nanoparticles by the endophytic Aspergillus terreus and evaluation of their antioxidant and antimicrobial activities. Appl Microbiol Biotechnol. 2021;105:741–753. doi: 10.1007/s00253-020-11046-4. [DOI] [PubMed] [Google Scholar]
- Muneer S, Memon S, Panhwar QK, Khushik F, Khokhar TS, Noo AA. Synthesis and antimicrobial activity of p-tetranitrocalix[4]arene derivative. Polycycl Aromat Compd. 2016;36:554–563. doi: 10.1080/10406638.2015.1033432. [DOI] [Google Scholar]
- Newman DJ, Cragg GM. Natural products as sources of new drugs from 1981 to 2014. J Nat Prod. 2016;79:629–661. doi: 10.1021/acs.jnatprod.5b01055. [DOI] [PubMed] [Google Scholar]
- Nisa H, Kamili AN, Nawchoo IA, Shafi S, Shameem N, Bandh SA. Fungal endophytes as prolific source of phytochemicals and other bioactive natural products: a review. Microb Pathog. 2015;82:50–59. doi: 10.1016/j.micpath.2015.04.001. [DOI] [PubMed] [Google Scholar]
- Ogilvie KK, Hamilton RG, Gillen MF, Radatus BK, Smith KO, Galloway KS. Uracil analogues of the acyclonucleoside 9-[[2-hydroxy-1-(hydroxymethyl)ethoxy]- methyl]guanine (BIOLF-62) Can J Chem. 1984 doi: 10.1139/v84-004. [DOI] [Google Scholar]
- Ol´shevskaya VA, Zaitsev AV, Kalinin AVN, Shtil AA. Synthesis and antitumor activity of novel tetrakis[4(closocarboranylthio)tetrafluorophenyl]porphyrins. Russ Chem Bull. 2014;63:2383–2387. doi: 10.1007/s11172-014-0751-z. [DOI] [Google Scholar]
- Parekh S, Vinci VA, Strobel RJ. Improvement of microbial strains and fermentation processes. Appl Microbiol Biotechnol. 2000;54:287–301. doi: 10.1007/s002530000403. [DOI] [PubMed] [Google Scholar]
- Pongtharangkul T, Demirci A. Evaluation of agar diffusion bioassay for nisin quantification. Appl Microbiol Biotechnol. 2004;65:268–272. doi: 10.1007/s00253-004-1579-5. [DOI] [PubMed] [Google Scholar]
- Praveen PJ, Parameswaran PS, Majik MS. Bis(indolyl)methane alkaloids: isolation, bioactivity, and syntheses. Synthesis. 2015;47:1827–1837. doi: 10.1055/s-0034-1380415. [DOI] [Google Scholar]
- Saha P, Talukdar AD, Choudhury MD, Nath D. Bioprospecting for fungal-endophyte-derived natural products for drug discovery. In: Singh B, editor. Advances in endophytic fungal research Fungal Biology. Cham: Springer; 2019. [Google Scholar]
- Salem MZM, Abdel-Mageed A, Ali HM. Stem wood and bark extracts of Deonix rigia (Boj EX. Hook): chemical analysis and antibacterial. Antifungal Anti-Oxidant Biores. 2014;9:2382–2395. [Google Scholar]
- Sallam AA, Houssen WE, Gissendanner CR, Orabi KY, Foudaha AI, ElSayed KA. Bioguided discovery and pharmacophore modeling of the mycotoxic indole diterpene alkaloids penitrems as breast cancer proliferation, migration, and invasion inhibitors. Med Chem Commun. 2013;4:1360–1369. doi: 10.1039/C3MD00198A. [DOI] [PMC free article] [PubMed] [Google Scholar]
- Shareef HK, Muhammed HJ, Hussein HM, Hameed IH. Antibacterial effect of ginger (Zingiber officinale) roscoe and bioactive chemical analysis using gas chromatography mass spectrum. Orient J Chem. 2016;32:817–837. doi: 10.13005/ojc/320207. [DOI] [Google Scholar]
- Skehan P, Storeng R, Scudiero D, Monks A, McMahon J, Vistica D, Warren JT, Bokesch H, Kenney S, Boyd MR. New colorimetric cytotoxicity assay for anticancer-drug screening. J Natl Cancer Inst. 1990;82:1107–1112. doi: 10.1093/jnci/82.13.1107. [DOI] [PubMed] [Google Scholar]
- Snyder SA, ElSohly AM, Kontes F. Synthetic approaches to oligomeric natural products. Nat Prod Rep. 2010;28:897–924. doi: 10.1039/C1NP00001B. [DOI] [PubMed] [Google Scholar]
- Sułek A, Pucelik B, Kobielusz M, Barzowska A, Dąbrowski JM. Photodynamic inactivation of bacteria with porphyrin derivatives: effect of charge, lipophilicity, ROS generation, and cellular uptake on their biological activity in vitro. Int J Mol Sci. 2020;21:8716. doi: 10.3390/ijms21228716. [DOI] [PMC free article] [PubMed] [Google Scholar]
- Sunassee SN, Davies-Coleman MT. Cytotoxic and antioxidant marine prenylated quinones and hydroquinones. Nat Prod Rep. 2012;29:513–535. doi: 10.1039/C2NP00086E. [DOI] [PubMed] [Google Scholar]
- Thaipong K, Boonprakob U, Crosby K, Cisneros-Zevallos L, Byrne DH. Comparison of ABTS, DPPH, FRAP, and ORAC assays for estimating antioxidant activity from guava fruit extracts. J Food Compos Anal. 2006;19:669–675. doi: 10.1016/j.jfca.2006.01.003. [DOI] [Google Scholar]
- Thirunarayanan G, Vanangamudi G. Synthesis, spectral studies, antimicrobial, antioxidant and insect antifeedant activities of some 9H-fluorene-2-yl keto-oxiranes. Spectrochim Acta A Mol Biomol Spectrosc. 2011;81:390–396. doi: 10.1016/j.saa.2011.06.027. [DOI] [PubMed] [Google Scholar]
- Venugopalan A, Srivastava S. Endophytes as in vitro production platforms of high value plant secondary metabolites. Biotechnol Adv. 2015;33:873–887. doi: 10.1016/j.biotechadv.2015.07.004. [DOI] [PubMed] [Google Scholar]
- White TJ, Bruns T, Lee S, Taylor J. Amplification and direct sequencing of fungal ribosomal RNA genes for phylogenetics. In: Innis MA, Gelfand DH, Sninsky JJ, White TJ, editors. PCR protocols: a guide to methods and applications. San Diego: Academic Press; 1990. pp. 315–322. [Google Scholar]
- Yoon II, Park HS, Cui BC, Li JZ, Kim JH, Lkhagvadulam B, Shim YK. Photodynamic and antioxidant activities of divalent transition metal complexes of methyl pheophorbide-a. Bull Korean Chem Soc. 2011;32:2981. doi: 10.5012/bkcs.2011.32.8.2981. [DOI] [Google Scholar]
- Zaki AG, El-Sayed ER. New and potent production platform of the acetylcholinesterase inhibitor Huperzine A by gamma-irradiated Alternaria brassicae under solid-state fermentation. Appl Microbiol Biotechnol. 2021;105:8869–8880. doi: 10.1007/s00253-021-11678-0. [DOI] [PubMed] [Google Scholar]
- Zaki AG, El-Sayed ER, Abd Elkodous M, El-Sayyad GS. Microbial acetylcholinesterase inhibitors for Alzheimer’s therapy: recent trends on extraction, detection, irradiation-assisted production improvement and nano-structured drug delivery. Appl Microbiol Biotechnol. 2020;104:4717–4735. doi: 10.1007/s00253-020-10560-9. [DOI] [PMC free article] [PubMed] [Google Scholar]
- Zhang Y, TangX SM. Unprecedented synthesis of aza-bridged benzodioxepine derivatives through a tandem Rh(II)-catalyzed 1,3-rearrangement/[3+2] cycloaddition of carbonyltriazoles. Chem Commun. 2014;50:15971–15974. doi: 10.1039/C4CC08339C. [DOI] [PubMed] [Google Scholar]
- Zhang L, Hua Z, Song Y, Feng C. Monoterpenoid indole alkaloids from Alstonia rupestris with cytotoxic, antibacterial and antifungal activities. Fitoterapia. 2014;97:142–147. doi: 10.1016/j.fitote.2014.05.018. [DOI] [PubMed] [Google Scholar]
- Zhang R, Lin Y, Yu H, Chen S, Zhou J. Partial synthesis of crassicauline A from yunaconitine. Nat Prod Bioprospect. 2020;10:105–108. doi: 10.1007/s13659-020-00238-0. [DOI] [PMC free article] [PubMed] [Google Scholar]
- Zhou X, Chen Q, Wang F. New C19-diterpenoid alkaloids from Delphinium trifoliolatum. Chem Pharm Bull. 2004;52:381–383. doi: 10.1248/cpb.52.381. [DOI] [PubMed] [Google Scholar]
Associated Data
This section collects any data citations, data availability statements, or supplementary materials included in this article.
Data Availability Statement
All data generated or analyzed during this study are included in this published article.



